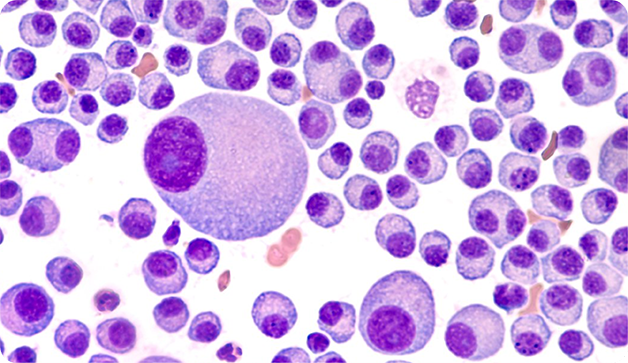

Liver Cancer
The liver, a major organ, in the body performs over 500 vital functions and i
Read More
Gallbladder Cancer
The gallbladder is a pear-shaped organ located right below the liver. The org
Read More
Oesophageal Cancer
The oesophagus or food pipe is a muscular, hollow tube that connects the mout
Read More
Osteosarcoma
Osteosarcoma is a cancer of the bones. It occurs when the cells in the bone b
Read More
Vaginal Cancer
When cancerous growth begins to develop in the vagina, it is referred to as <
Read More
Vulvar Cancer
The vulva refers to the female external genitalia. It is composed of labia ma
Read More
Uterine Cancer
The uterus or womb, a pear-shaped organ, is located in the pelvis between the
Read More
Bladder Cancer
Bladder cancer refers to the condition in which the cells in the bladder begi
Read More
Multiple Myeloma
Multiple Myeloma, also called, Kahler’s disease is the development of cance
Read More
Pituitary Tumor
The pituitary or master gland produces hormones in the body. When cancerous g
Read More
Ovarian Cancer
Ovaries are two almond-shaped egg-producing female reproductive organs situat
Read More
Cervical Cancer
A cervix refers to an opening between the vagina and the womb. A cancerous gr
Read More
Breast Cancer
The breasts are composed of various tissues. These tissues are also connected
Read More
Thyroid Cancer
Thyroid cancer develops in the thyroid glands. It is more commonly seen in wo
Read More

















